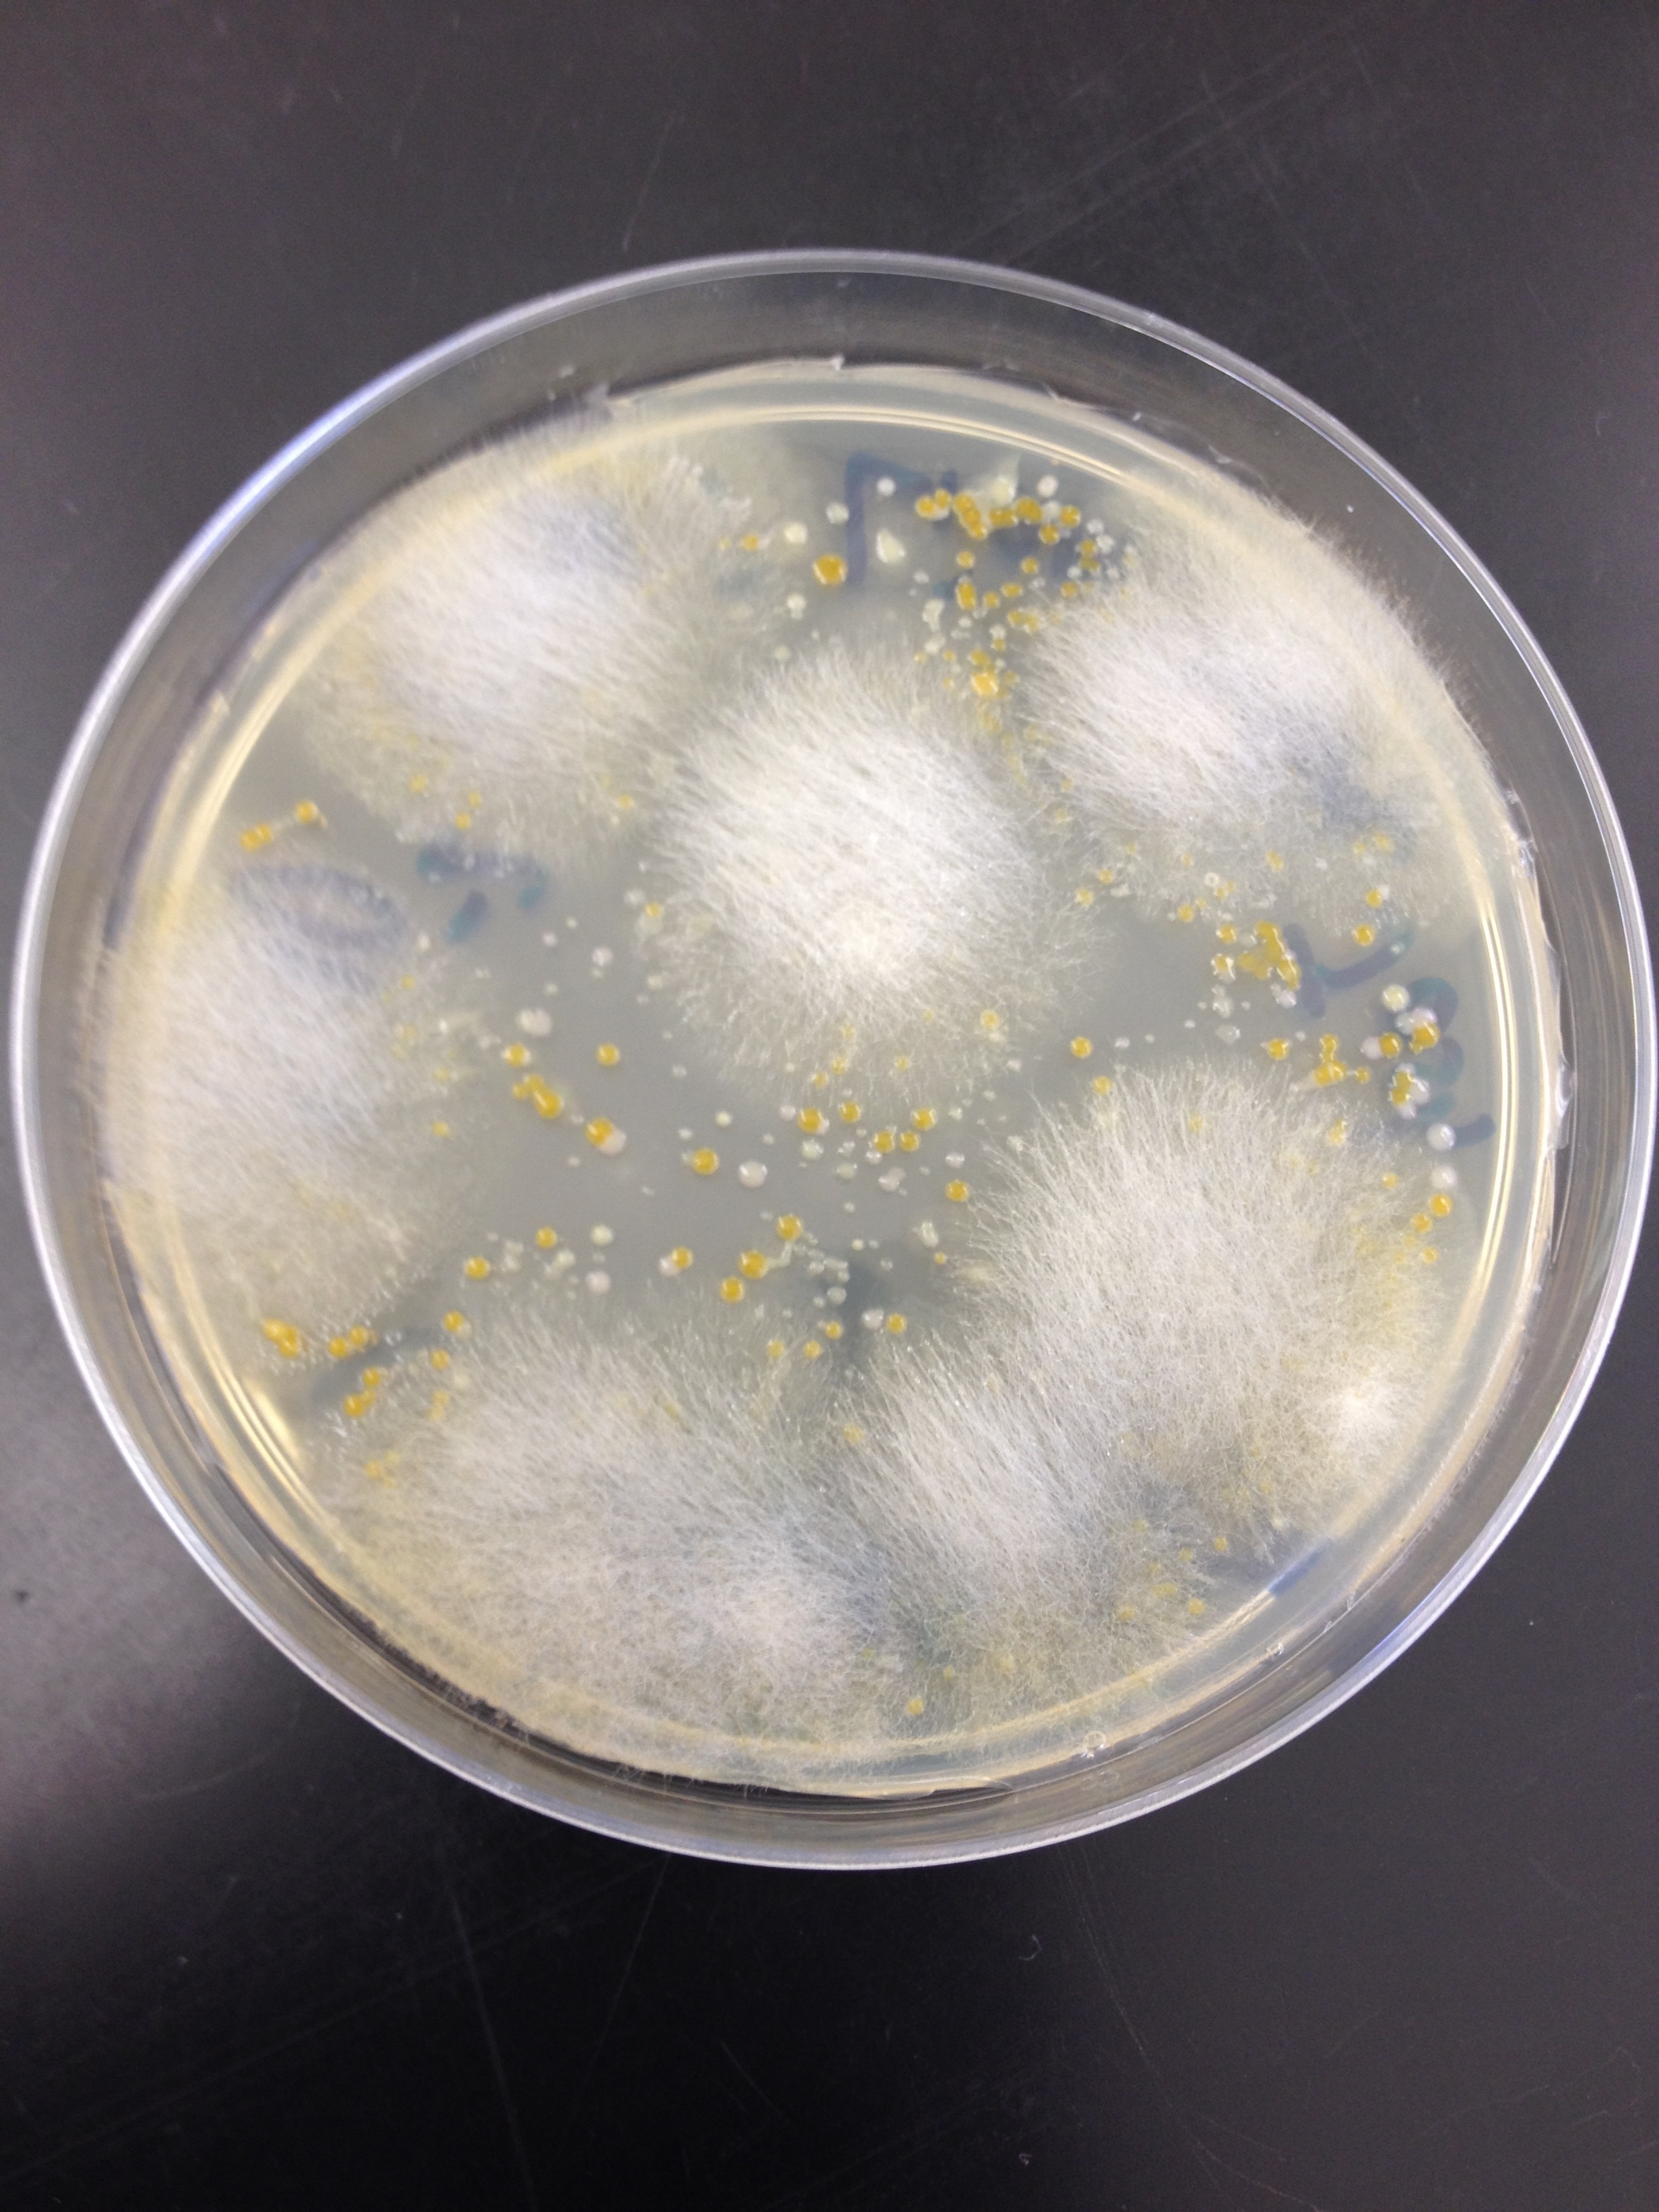

User:Liam Purdy/Notebook/Biology 210 at AU
March 11, 2015
Final Observation of Zebrafish, Day 14
Upon entering lab on day 14, only one dish remained with fish in it. This was the dish containing the Rhodamine. A sample was taken out, examined, and characteristics of the fish were noted.
The fixed samples were also observed on this day. Tail length, eye diameter, and length of the entire zebrafish were measured.
All live fish that were not put into chemicals were put into one bowl, while all infected fish were put into another, and the dead fish were fixed.
Photo1: The following photo is of the data collected from the observed fish on the final day of the Zebrafish lab.
Table 4 shows the data collected on the last day of the experiment. As previously discussed, the sodium fluoride and control fish had been mysteriously lost by this time in the experiment, leaving only the Rhodamine fish. Most of the fish had died either from outside disturbance, lack of food, or from the chemical itself. Movement in these fish had dropped to almost nothing, and some even seemed to be shaking violently without moving anywhere at all. Most fish would only move if physically relocated by the pipette. One occurrence mentioned in Gogh and Neff’s paper was that the tadpoles could be swirled into the middle. This was the same result for the now seemingly paralyzed fish. A heart was now visible in these fish and it beat at 40 BPM.
Another task taken on for the last day of the Zebrafish lab was comparing the fixed fish of day 7 and day 14.
Photo 2:
The photo below is of the fixed zebrafish from day 14. This fish came from the Rhodamine dish.

The fish has obviously made some great developments over the past week when a fish was initially taken from the same dish. A heart was no visible as well as a swim bladder and pectoral fins.
The developmental progress of the two fish were compared in a chart.
Photo3:
The following photo is of the comparison chart between the Rhodamine fish that was fixed on day 7 and the fish Rhodamine fish that was fixed on day 14.

Table 5 discusses how the growth of the Rhodamine exposed fish had progressed between days 4 and 14. Since that was the only group of fish to survive the whole experiment, it was the only one that could be compared to its original state of development. Upon looking at the table, one can see that the fish were able to grow fully to the end of they’re embryonic stages, growing a swim bladder, a mouth, and even pectoral fins to help them move. The original fish on day 4 had none of these features, and used its tail in a whip-like fashion to move it around the bowl.
Conclusion: The hypothesis of this experiment was that the fish exposed to chemicals would eventually become immobile as a result of the exposure. While the Rhodamine fish did lose mobility, this information cannot be used to claim the hypothesis correct without the existence of a control group at the end, or the knowledge of what happened that led to all of the fish disappearing. According to the literature examined prior to this experiment, the introduction of Fluoride should have had a profound impact on the mobility of the fish, however, those fish did not make it to the final observation day.
-LP
March 8, 2015
Zebrafish day 11
An error in communication amongst the group led to n data being collected on this day for the fish. We cannot say if any growth or development had come about on by this day, or any significant changes in the morphology of the fish because they weren't observed.
Had any fish been observed on this day, all dead fish would be removed from each dish. The characteristics of each fish would be recorded into a chart much like the other days. Also, 10 mLs of water would be added to the control dish, as well as 10 mLs of water and testing chemical to the chemical dishes.
-LP
March 4, 2014"
Zebrafish day 7
On day 7, any dead fish or empty sacs were removed from each dish in order to avoid complications in the experiment. 10 mLs of Deerpark water were added to the control, and 10 mLs plus the test chemical were added to the other two dishes. One drop of paramecium food was added to each of the dished.
Similar observations as day 4 were made from the hatched zebrafish, and recorded in a chart.
A final action taken on this day was the fixing of samples from each dish. Each sample was placed into a tube and 1 drop of trichinae solution was added with it. The TA added paraformaldehyde to the tube and fixed the live samples.
Photo 1:
The photo below is of a table that was created using the data collected from day 7 in the lab

Photo 2:
The photo below is of one of the fish that were fixed from the Rhodamine dish.

Table 3 shows the fish on day 7, when each had reached the developmental stage D. The hypothesis of this experiment appears to start gaining support by this point in time because the response time of the fish in the chemical liquids appeared to be slightly off from the fish in the control group. Movement styles stayed the same between all three trays, and the size gap increased, significantly, which may have been the beginning sings of stunted growth in the chemical exposed fish. Color began to appear on the fish at this point as well, showing smaller spots of green on a black body.
-LP
March 1, 2015
Zebrafish day 4
The dishes were checked for any hatched fish on day 4. 10 mLs of the liquid in each dish were removed, as well as any empty egg sacs. The sacs were removed in order to keep mold form forming in the habitats. 25 mLs of each respective fluid was then added back into each dish to compensate for the removed liquid, and any liquid lost during the removal of the egg shells.
Dead Embryos were saved in paraformaldehyde. The number of living, dead, unhatched, and hatched embryos were recorded into a chart. Unhatched and and hatched zebrafish were then examined under a microscope for the following: Degree of pigmentation, eyes, heart and heart rate, pectoral fin development, development of the swim bladder, development of a mouth, movement. Movement was also tested by poking at the fish with a transfer pipette to see the fish's response time to stimuli in their environment. - Photo 1: The photo below is of a graph made after the data collection for the Zebrafish's growth and development on day 4.
When the table above is analyzed, it is clear that only 2 fish were actually lost in the hatching process, which put the experiment off to a good start with a wide population of fish to observe. Since it had only been 4 days of exposure to the chemicals, the fish did not seem to have any unusual behavior in movement or even in their physical development. As seen by the “Eye Diameter” box, the fish all had relatively the same eye size. The only difference between the control and the other two groups was the size of the whole fish, however, it could be that the control fish had just managed to grow more in the short amount of time, and cannot necessarily defend the claim that the two chemicals can stunt growth.
-LP
February 25, 2015
Enter the Zebrafish
The lab that was carried out this week was focused on the impact that exposure to certain chemicals could have on the development and growth of organisms in the embryonic state.
The first step in this experiment was reading a published paper that would potentially pertain to the desired test chemical. The paper that was chosen was “Effects of fluoride on Xenopus embryo development”, which concerned the use of tadpoles, not zebrafish. A general plan was made for carrying out this experiment, along with a hypothesis for the results.
Next, 3 dishes were collected for the three solutions that would house the zebrafish eggs. The first petri dish was filled with 20 mL of Deerpark water, the second dish was filled with 20 mL of Sodium Fluoride, and the third dish was filled with a diluted Rhodamine; 200 microliters of Rhodamine with 18 mL of Deerpark Water.
The next step carried out was the selection of 20 clear, healthy zebrafish eggs for each of the petri dishes. Eggs were put into large bowls and healthy ones were individually selected and placed in each dish by using a transfer pipette
The first day was centered around getting the plates organized, and a table was made to just take the setup better understood.
Photo 1:
The following photo is of a chart of the initial experimental set-up data.

Photo 2: The photo below is a close up shot of what one egg looked like under the microscope. It is believe to be in the embryonic phase M.
-LP
March 4, 2015
16S Sequence Analysis
The DNA of our bacteria from the third lab, Microbiology, was sequenced. This was done by first transferring a single colony of bacteria into 100l of sterile water. Next, the water and bacteria were incubated at 100 degrees celsius for 10 minutes. The samples were then centrifuged for 5 minutes at 13,400 RPM. While the centrifuge was running, 20ul of primer and water were added to a PCR tube; the PCR bead was dissolved. The supernatant from the centrifuge was then transferred to the 16S PCR tube and the tube was placed in the PCR machine. This process will allow the DNA sequence to be read and recorded, which can later be blasted to find the organism that it codes for.
The sequencing results came back as follows:
10^-3 Sequence: NNNNNNNNNNGNNGCNNNNNTGCAGTCGAACGGGGTANGCGTAANGCTGCTNCTAGAGGGGGAGAGGGGTGCGTGAGGGC NNAGCGTCTGACTGACCGCGGGAGAGGGGTTGAAANAGGAACGCTAAAACCATGAACGTCACAGAGGAAAAGGCGGGAGA CGGTGGCCTTTTGCTCTATTTAATGATNATGGGTGGGAGCCCGAGANGGTGGTGGTNNTCNCCGTAANGGNAAGATGTAT ATGGGGTCAGAGAANAAGCTNAGACNCAGAGAAACTGAGACAGCGTCCAGACTCATACGGGGGGNGGGTGTGGAATTTGG GGCAATGGGGGAAAGGGCCATATCCAGCCGTGCCGCGTGTGCGAAGAACGCCTGAGTTTTGCCCTGCTTTTTGTCTTGNG ATGAAGGCCAGGAATAAAATATTCTACNCTTGTGATTCTGACTGTACAAAAAGAATAAGGACCGGCTAACTCCGTGCCCG CAGCCGCGGTAATACGGAGGATGCTAGCGTTATTCAGATTTATTGGGTTTAACGCGTGCGTATGCGGTCTTTTAATTCAA TGGTCAAATACTCTACCTCAACTGTCGCATTGCCTTTGATACTGTAGTACTTGAGTCTGTTTGANGTGNGTGCAATTACA CGTGTAACGGTGATATNCATANATATGTCNNGGANCTCCNATTGCGNNNGCCTCTCCCTANNCTNNCACTGACGCTNATG CACGAANGNNNNNGGATCGAACAGGATTACATACNCTCNNNNNCCACNCCCTANACAATTATAACTTGATGTTTGNNAAG ACAAAANNCTNCCCNCCCNCCCCAANCNTTTNNTTNNTNNNCCTNNGGAGGAGGNNCNCCCNGGTGAANACTCNNNNGNN TTTNNNNNCNGNCNNCACNCNCNCANNANNNGNNNNNNNNNNNNNNTNATACNNNAANNAACCNTGCNNCCCCTCCTTNN NNNNNGGGGGNNGNGGANAANNANNNNNNNNNNGNTNNNNNNNNNNANGANGNAANNNNNNNNNGGNGGGGNNNNNNNNN NNNNNNNTNTTNNTANNNNNANNNGGNGNNNNNANCNNCNNNNNGTNNNNN
10^-3 tet Sequence: NNNNNNNNNCNTANNNTGCAGTCGTANCAANGTAGCCNNNNNNTCCTGGCGGCGAGTGGCGAACGGGTGAGTAATACATC GGAACGTGCCCAATCGTGGGGGATAACGCAGCGAAAGCTGTGCTAATACCGCATACGATCTACGGATGAAAGCAGGGGAT CGCAAGACCTTGCGCGAATGGAGCGGCCGATGGCAGATTAGGTAGTTGGTGAGGTAAAGGCTCACCAAGCCTTCGATCTG TAGCTGGTCTGAGAGGACGACCAGCCACACTGGGACTGAGACACGGCCCAAACTCCTACGGGAGGCAGCAGTGGGGAATT TTGGACAATGGGCGAAAGCCTGATCCAGCCATGCCGCGTGCAGGATGAAGGCCTTCGGGTTGTAAACTGCTTTTGTACGG AACGAAACGGCCTTTTCTAATAAAGAGGGCTAATGACGGTACCGTAAGAATAAGCACCGGCTAACTACGTGCCAGCAGCC GCGGTAATACGTAGGGTGCAAGCGTTAATCGGAATTACTGGGCGTAAAGCGTGCGCAGGCGGTTATGTAAGACAGTTGTG AAATCCCCGGGCTCAACCTGGGAACTGCATCTGTGACTGCATAGCTAGAGTACGGTAGAGGGGGATGGAATTCCGCGTGT AGCAGTGAAATGCGTAGATATGCGGAGGAACACCGATGGCGAAGGCAATCCCCTGGACCTGTACTGACGCTCATGCACGA AAGCGTGGGGAGCAAACAGGATTAGATACCCTGGTAGTCCACGCCCTAAACGATGTCAACTGGTTGTTGGGTCTTCACTG ACTCANTAACNAAGCTAACGCGTGAAGTTGACCGCCTGGGGAGTACGGCCGCAAGGTTGAAACTCAAGGAATTGACGGGG ACCCGCACNAACGGTGGATGATGTGGTTTAATTCNATGCAACNCNAAAAACCTTACCCACCTTTGACATGTACGGAATTC NNCAGANNTNGCTTANGGCTCNAANNANAACCGTTACACNGNTGCTGCATGGNNGTCNTCAGCTCGTGTCNNGAGNNNNT NGGGNTAANTCCCGNAACNAGCNCNNACCCNNTGNNN
Photo 1:
The following image is of the Gel from the PCR process. The second columns belong to Transect 3 organisms, the top column is the ladder.

The first blast that was done was of the 10^-3 plate without the TET. Unfortunately, when the blast came back with a non responsive result, meaning that the bacteria was not able to be identified by the program. this could have been a problem in the PCR process, or an insufficient amount of DNA, or DNA from multiple species in the PCR reaction that confused the results.
The second reaction, the bacteria from the plate with a 10^-3 concentration and TET present, came back with a positive result. The resulting organisms that the sequence was linked to was a bacteria called "Variovorex Paradoxus". This bacteria is gram-negative, and has an important role in the biodegration of dead matter in nature.
The sequencing was important to the Transect lab because it once again allows us to understand what organisms are living in the environments around us. The key concept of this lab is gaining the ability to be able to identify, locate, and understand various organisms, and the right steps to take in order to start the identification process. Learning to create a PCR reaction to identify a DNA sequence is another vital step in identifying organisms.
-LP
March 4, 2015
Food Web
One great opportunity that was presented through the transect lab over the past few weeks was that it forced attention towards nature and the organisms living within it. After the first interaction with the transect, I found myself connected to it, as though it were my own plot of land that I had to take care of. While walking between Bender Arena and Leonard Hall, I started making sure to change my route so that I would be able to take a look at the condition of my transect, making sure that nothing was torn up or damaged.
The observation labs that were required parts of this lab section also revealed the wide variety or organisms that inhabit the transect. From the larger, more obvious organisms like the birds that are just flying through and the squirrels that inhabit the trees, to the smaller protists and microorganisms that inhabit the fallen leaves of the transect floor, this lab has made it more apparent that there are living creatures everywhere whether visible or not.
Photo 1:
This photo was taken as I was walking between Bender and Leonard Hall. It took me 10 minutes, complete silence, and a lot of chasing to get this.

Based off of the observations of this lab, as well as visual observations from just passing through the transect, a food web is able to be made to show how the organisms rely or feed off one another in order to create a stabilized and functioning ecosystem.
Photo 2:
The photo below is a hand drawn food web. This is how I believe the ecosystem functions. Included is the Name, Phylum, Class, and Species of 5 of the organisms.

Some abiotic factors that help the survival of the various organisms is the water found in the soil as well as the soil which help the plants to live. The plants benefit the vegetarian organisms which in exchange are food sources for the carnivores of the ecosystem. This is just one example of how the Transect forms a functional ecosystem in which living organisms depend on abiotic features to keep balance in the environment.
These organisms represent a community or various organisms that are living together in stability. They also represent carrying capacity because the examination of how many organisms are actually present in an ecosystem, whether they be visible or microscopic, shows just how large and complex an ecosystem is. Finally, using the food web, the trophic levels of the ecosystem can be organized. There are various levels of the food chain depicted in this transect, and the food web presented is just one small portion of it.
-LP
February 19, 2015
Lab 5: Invertebrates
The primary purpose of this laboratory experiment was the become familiar with the different types of invertebrates, as well as to understand their common existence in our transects. This was accomplished by using a Berlese Funnel that would lead to a sample collection of the variety of invertebrates that could be found within our transect. Samples were taken from the top and bottom of the ethanol collection tube, which provided organisms in a variety of sizes.
The setup for the funnel was as follows: First, 25 mL of half ethanol, half water solution was pored into a 50mL conical tube. Next, the collected leaf liter form the transect was placed into a large funnel with a wire screen in the bottom. This screen allowed small organisms to fall out of the funnel, while keeping the plant litter from escaping. The spout of the funnel was then put into the the tube, not touching the solution at the bottom. The two components were then taped together and securely fastened to a stand so that the Berlese Funnel would not tip while being left to sit. A 40 Watt lamp was then placed over the funnel and left on. This would dry out the collection of snow-moistened leaves and would also dry out any tiny invertebrate organisms that were living in the leaf collection. Tin foil was put over the fun land lamp to keep heat concealed.
Photo 1:
The photo below is a hand-drawn rendition of the Berlese Funnel.

The contents of the ethanol were then examined under a dissecting microscope to see what organism samples existed in the litter.
Photo 2:
The following photo is of a table from the lab book that recorded the findings of the Berlese Funnel.

Another portion of this lab was the exploration of different types of worms; Acoelomates, Pseudocoelomates, and Coelomates. When I find out how to post a video, I will post a video of the Flatworm Moving. The Flat Worms seemed t slither around their tray in order to move. The Pseudocoelomates moved by wobbling from side to side in a spastic, random motion. Finally, the Annelida earth worms moved like a common worm found in the soil would; scrunching up the mid section in order to propel forward or backwards; this helps the Earth Worm to move through the soil easily.
-LP
February 11, 2015
Lab 4: Plantae and Fungi"
The purpose of this lab was to explore the differentiating characteristics between plants and fungi. Another requirement for this lab was to once again get involved with the Transect environment and collect leaf samples for the following week's lab.
The first requirement for this lab was to enter our transect again and collect various leaf samples from the ground and from bushes. The plants form the ground were collected in bulk into a bag, and would be later set up to create a Berlese Funnel. The other leaves would be used to examine the various characteristics and types of leaves in the transect group. The collective details of these plants was summarized in Table 1 of the lab manual.
Photo 1:
This table summarizes the plant collection process and the characteristics of the acquired plants.

Each plant was selected for its uniqueness in comparison to the others. The locations of these plants can be accurately seen by using the hand-drawn map from the first laboratory entrance.
Photo 2:
This plant sample was taken from a tree in the North West portion of the Transect. As you can see, the tree still has numerous green leaves on it, showing that it is able to survive the cold winter months when many trees and other leaf-carrying plants shed their foliage. The leaves grow off the branch in bunches of 5.

Photo 3:
This sample was taken from a low lying, bush-like plant in the southern corner of the transect. These bushes grow all over the floor, covering the whole ground area in a thick, intertwined jungle. The plant is generally on long stalk of leaves on either side.

Photo 4:
This leaf sample was taken from a larger bush that is also located in the Southern corner of the Transect. This medium sized bush still had many of its leaves attached which is why it was selected for examination.

Photo 5:
This sample was taken from a very tall, spiny bush in the South eastern corner of the Transect. Most of the leaves on this one had fallen off. However, it was the fact that this particular bush looked so different from the other samples that it was selected to be observed in this lab.

Photo6:
This final sample was taken from the North East section of the Transect, from a very large bush that still had numerous leaves on it. This bush had lost many of its leaves that were present in the warm weather, but the ones that were retrieved were still green. Each branch, however, only held one or two of these leaves, showing that they were probably about to fall as well.

-LP
February 4, 2015
Lab 3: Microbiology
The purpose of the Microbiology lab was the ability examine colonies of bacterium under a microscope, and how to accurately perform tests that allow for identification of the characteristics of a bacteria cell. The test that was to be carried in with this lab was a Gram Stain test, which tests for the existence of peptidoglycan in the bacteria's cel walls; a pink stain is negative and a purple stain was positive. Finally, a PCR for 16S sequencing was also prepared.
The first instructions given during this lab were to retrieve the Hay Culture and to make observations regarding how it has changed since last week. Firstly, the scent of the water, while still terrible, was not as rotten as it had been the week before, although the scent now lingered in the nostrils for a lot longer after smelling. Secondly, there was a drastic decrease in the volume of the water in the ecosystem. What this most likely means is that as more and more bacterial colonies come to exist in the Hay-Infusion, resources will begin to get more and more scarce as competition for survival increases. The water has turned a murkier dark brown and all the leaves have fallen to the bottom of the jar. A final noticeable change in the ecosystem is the presence f a thin, brown and black spotted layer floating on top of and on the walls of the water and jar. This is clearly a new bacterial colony that may require light for nutrients; this would explain why they lie on the top of the water, where light would come to them easiest.
Your notebook is very complete, keep it up! Please try to make your photos smaller, it will be easier for you to use the notebook in the long run. ML
Photo 1:
The following image is a side-view photo of the Transect 3 Hay-Infusion Culture after 2 weeks of sitting.

The next set of observations were based off of the AGAR Nutrient Plates that were prepared last week at the end of the lab period. Each plate contained a different concentration of bacteria, and 4 of the 8 plates were coated in TET, an antibiotic. Bacteria grew on every plate regardless of the presence of the antibiotic. What this indicates is that the bacteria that formed on the TET plate must have had a genetic mutation that granted immunity tot hat particular antibiotic. This resembles a huge issue that is currently plaguing the scientific community today; the release of antibiotics into nature is causing super bacteria that cannot be easily destroyed with conventional medicine. Colonies that grew on the plate ranged in characteristics (other than shape, all were bumped circles). Some colonies were incredibly small while others were very large, some were orange while others were white or a creamy vanilla. One cool growth on the plates was of a white hairy fungus. From my observations, I saw that while there was a significant drop in the number of existent colonies on the plates coated in TET (As shown in picture 3), the plates tended to have larger colonies of bacteria and more fungus growth than than the plates without the TET.
Photo 2:
The image below is of an AGAR plate with bacterial colonies and fungus.
Photo 3:
This is a photo of the 100 Fold Serial Dilution results. This is a chart that records the probable amount of bacterial colonies on the AGAR plate.

The next part of this laboratory experiment was to examine the bacterial colonies under a microscope and to Gram Stain them in order to find the existence of peptidoglycan. In this process, my group chose to examine one colony from four plates, 10^5 TET and no TET, and 10^-3 TET and no TET. Colonies were collected from the plates using a sterile loop and placed onto a wet mount slide. The colony was then looked at through a microscope and different t bacteria and there traits were recorded on a chart (photo 4). Once each plate had an examined colony, the Gram Stain test was prepared. By following the steps that were listed on the paper next to the staining station, we were able to successfully carry out the Gram Stain process. The process of the gram stain included drying out a bacterial colony on a glass slide, then washing over the each slide with a variety of dyes that eventually left the colony with a purple or pink stain, which shows the presence of peptidoglycan. We then examined the slides of bacteria again under the microscope. This time, some of the bacteria had a pink stain, while others had a purple stain. The purple stained bacteria had tested positive for peptidoglycan in its cell walls. The only one that tested positive was the slide from the 10^-3 with TET. This could signify some sort of relationship between high amounts of peptidoglycan and an immunity to certain antibiotics.
Photo 4:
The picture below is a chart that lists the characteristics of the bacterial colonies when examined.

Photo 5:
The picture below a photo of gram negative bacteria through a microscope.

Photo 6:
The photo below is another picture via the microscope of a Gram positive bacteria.

The final part of this lab was to set up a PCR for 16S sequencing. Due to time restraints, my group was only able to make 2 tubes of DNA to be amplified. In the next lab, we will use Agarose gel to find if there is PCR present. If there is, we will be able to purify our DNA for sequencing, which will allow us to identify the bacteria that was present in our ecosystem. The PCR tubes were set up by incubating 100 ul of water and a bacterial colony in 100 C water for 10 minutes. The samples were then centrifuged for 5 minutes while a PCR/ Water tube was prepared. The supernatant was then transferred to the 16S PCR reaction. This was allowed to sit until the next lab. -LP
January 28, 2015
Lab 2: Identifying Algae and Protists
Very complete information so far, great job. Having photos to ID your protists would be helpful. Otherwise, very complete. Keep it up! ML
The main focus of laboratory 2 was to gain the ability to properly identify the differences between protists and algae. In specific, the ability to correctly use a dichotomous key to accurately identify microscopic organisms. Our group was instructed to collect water samples from various areas of our Hay-Infusion ecosystems and analyze the slides under a microscope. We then had to identify the organisms present in each slide using the dichotomous key.
Once our Hay-Infusion was retrieved, the lab book instructed us to analyze how it looked and smelt. The smell was absolutely terrible, resembling only what can be described as an old garbage can left in the sun. The water that was originally clear has turned a disgusting murky green/brown. The soil that we had collected had sunken to the bottom of the mixture and some of the heavier leaves floated in the middle. On top where lighter leaves that had turned a blackish color that showed that they were breeding ground for bacteria. While no visible mold or bacteria were present, on the water, the sides of the jar had gathered a creamy white looking substance that was more than likely mold. Also, the top layer of the jar seemed to have a thick film over it, again probably containing numerous types of bacteria.
Photo 1:
This is a photo of my group's Hay-Infusion after sitting for a week (side view).

Photo 2:
This is a photo of our Hay-Infusion after sitting for a week (top view).

We decided to collect three samples, instead of only two, from the top of the ecosystem, the middle off of a sunken leaf (the leaf had sunken from the top of the Hay-Infusion when the transfer pipette was taking samples from the bottom of the ecosystem. This is why we decided to take a middle sample.), and the bottom from the top of the settled soil. Once each sample was examined, we used the dichotomous key to identify the organisms that we saw. The top sample contained Colpidium (55um), Chlamydoma (9um), and Eudorina (7um). The middle sample contained Colpidium from the top of a sunken leaf. The bottom sample contained Colpidium and Actinospherium (73um). Each of these organisms were motile, which made it slightly difficult to effectively classify them. If our culture was left to grow for 2 more months, and hopefully it will be, I believe that a whole new variety of bacteria would appear, and even more complex ones than the ones that are currently present. I believe that a lot of mold would be present in the jar and in the water, and the water line of the jar would drop drastically. I believe that the leaves would begin to deteriorate from being broken down be the bacteria and the water. Pressure put on the ecosystem would begin to multiply with a drastic increase in the amount of organisms present in the ecosystem. The organisms will have to fight for food and nutrients while also getting the best spots to attract the most light for photosynthesis to occur. The final part of this lab was to create and plate a serial dilution of our Hay Infusion Ecosystem. This was done by first swirling the Hay Infusion, and then removing 100 ul and transferring it to 10 mLs of sterile broth. This created a 10^-2 dilution in this tube. 100 ul of the 10^-2 diluted to a second tube of 10 mL sterile broth; this created a 10^-4 dilution. This process was then repeated two more times for a 10^-6 and 10^-8 dilution. 100 ul of each diluted test tube were then put on two separate agar plates, one with the antibacterial, Tetracycline, and one without it. The diluted mixture was then spread around their respective plates and allowed to grow for the next week.
Photo 3:
This is a hand drawn photo of the serial dilution process:

Photo 4:
The following photos are hand drawn pictures of the protists found in the different layers of the Hay Infusion Culture.

-LP
January 25, 2015 Liam Purdy:
Lab 1: Biological Life at AU
In today's lab, we examined the variations in organisms of the same species that can occur due to evolution. In specific, we examined specimens that were each members of Chlorophyta, a green algae group. The specific line that was examined was the Volvocine Line. Three members of this line were examined in this experiment in order of their evolutionary complexity; Chlamydomonas, Gonium, and Volvox; characteristics of group of organisms were then recorded in the lab book.
The second portion of this lab was to go outside and examine our group's designated transects. My group received Transect 3, which was located by the bronze AU Eagle statue and referred to as "Tall Bushes". Transect 3 is located right outside of AU's Bender Arena and is the surrounding environment to a small circle with benches for students tot sit and relax in. Because the are has tall foliage, it isn't uncommon for smoking students to enter this secluded area, which in turn means that cigarettes butts are a common cite. The transect is surrounded by concrete sidewalk with more natural features in the center. The middle of this transect is comprised of multiple bushes of various sizes that range from very short, floor hugging bushes to taller thornier bushes. The ground is made of wood chip and dirt, which was relatively frozen due to the recent snow storm.
Photo 1:
This photo is taken from the South corner.

Photo 2:
This photo is taken from the East corner.

Photo 3:
This photo is taken from the North corner

Photo 4:
This photo is taken from the West corner.

Photo 5:
The following image is a hand-drawn arial view of transect 3:

While at our Transect, our group took note of the biotic and abiotic features of the area.
Abiotic Factors: Lampost (2x) Sidewalk/ Concrete Sprinklers (3x) Soil Snow and ice Electrical wires (For the lampposts)
Biotic Factors: Tall and short bushes Wood chips Fallen leaves Low-lying Plants 1 tall tree
In the final part of this lab, each group was instructed to collect various biotic and probiotic specimen from their transects. We were then told to take 10 grams of our collected sample and put it in a jar of 500mL water and .1 g dried milk powder. The mixture was then swirled and let sit or the next week.
Great job compiling all the information and organizing it. Thanks for including the volvocine line information too. Keep up the good work. ML
-LP
January 21, 2015
Revelations
Liam Purdy. Now I found the way!
-LP



